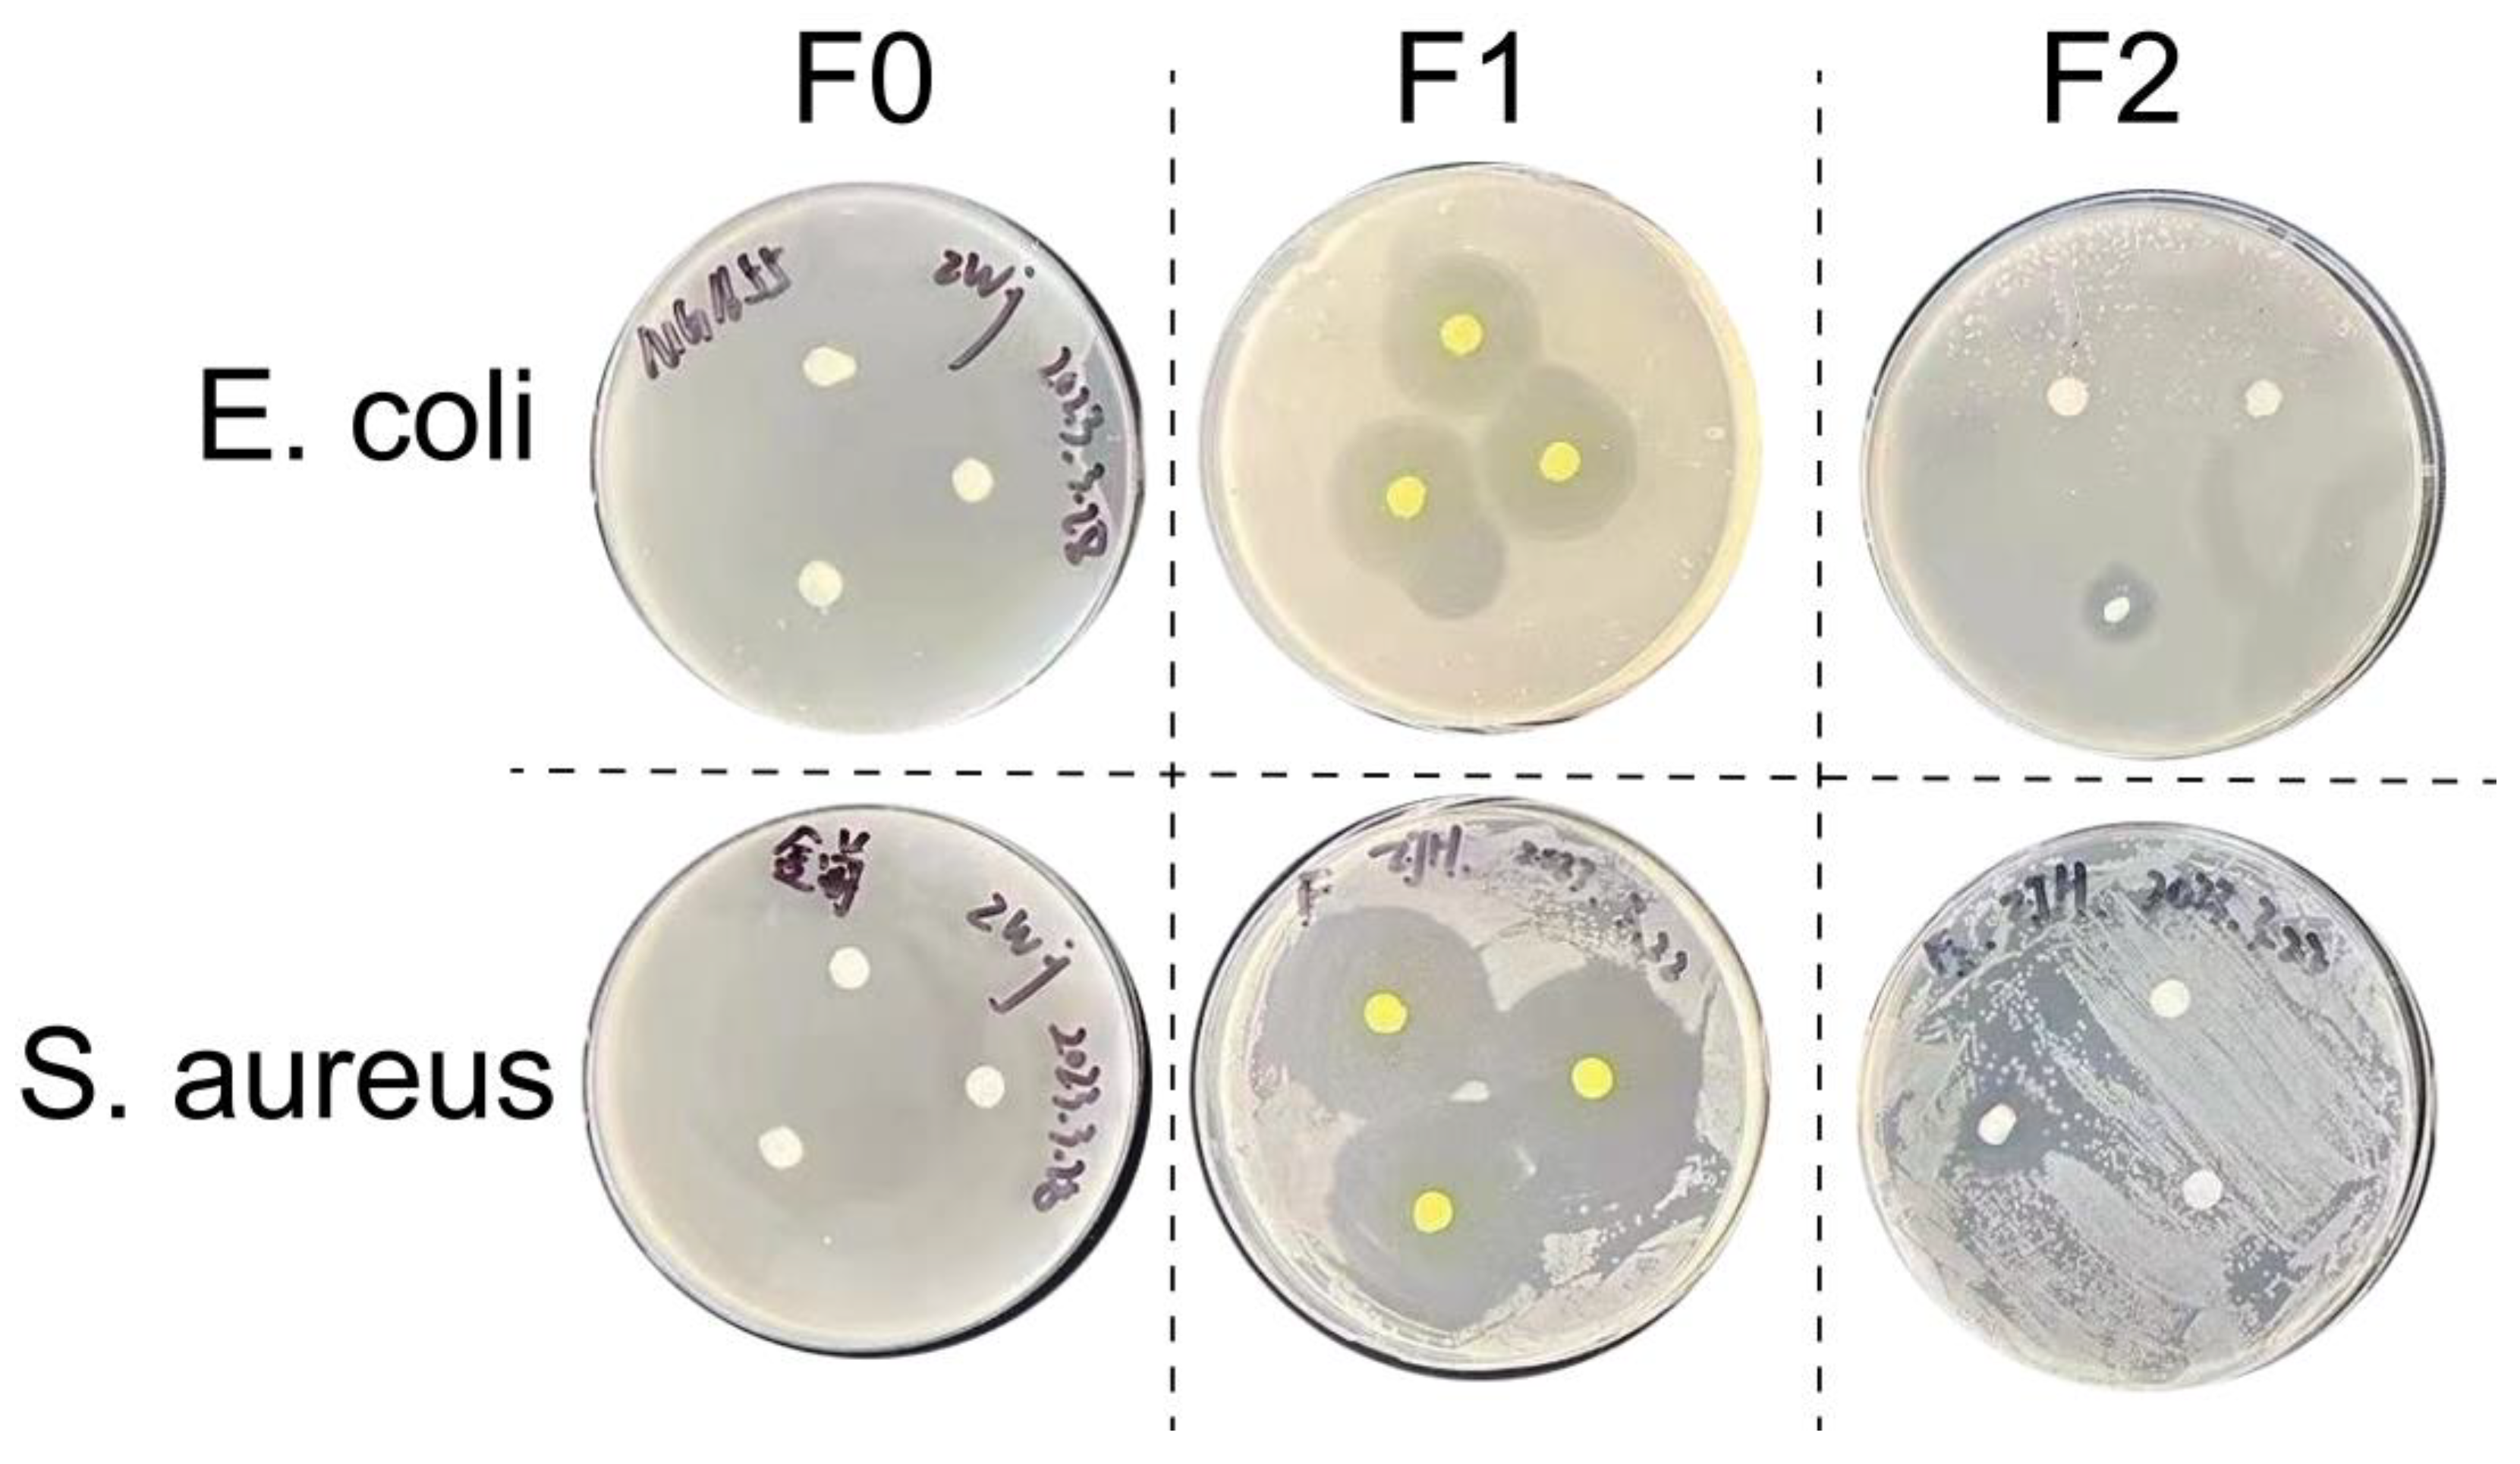
Membranes 14 00095 g006

Preparation and Investigation of Cellulose Acetate/Gelatin Janus Nanofiber Wound Dressings Loaded with Zinc Oxide or Curcumin for Enhanced Antimicrobial Activity
Abstract
1. Introduction
2. Materials and Methods
2.1. Materials
2.2. Preparation of Nanofiber by Electrospinning
2.3. Characterization of Janus Nanofiber Surface Structure
2.4. Characterization of Janus Nanofiber Constituents
2.5. Wetting Property Analysis
2.6. Mechanical Properties Analysis
2.7. In Vitro Drug Release Process
2.8. In Vitro Antimicrobial Performance Testing
3. Results
3.1. Structure of Janus Nanofiber
3.2. Composition of Janus Nanofiber
3.3. Wetting Properties of Janus Nanofibers
3.4. Mechanical Properties of Janus Nanofibers
3.5. In Vitro Drug Release
3.6. In Vitro Antimicrobial Properties
4. Conclusions
Author Contributions
Funding
Institutional Review Board Statement
Data Availability Statement
Acknowledgments
Conflicts of Interest
References
- Jiang, X.; Zeng, Y.-E.; Li, C.; Wang, K.; Yu, D.-G. Enhancing Diabetic Wound Healing: Advances in Electrospun Scaffolds from Pathogenesis to Therapeutic Applications. Front. Bioeng. Biotechnol. 2024, 12, 1354286. [Google Scholar] [CrossRef]
- Riaz, Z.; Baddi, S.; Gao, F.L.; Feng, C.L. Gallic acid-doped multifunctional hybrid hydrogel for antioxidant and antibacterial studies. Eur. Polym. J. 2024, 206, 112778. [Google Scholar] [CrossRef]
- Yan, S.; Qian, Y.; Haghayegh, M.; Xia, Y.; Yang, S.; Gao, R.; Zhu, M. Electrospun Organic/Inorganic Hybrid Nanofibers for Accelerating Wound Healing: A Review. J. Mater. Chem. B 2024, 12, 3171–3190. [Google Scholar] [CrossRef] [PubMed]
- Shi, Y.; Zhang, Y.; Zhu, L.; Miao, Y.; Zhu, Y.; Yue, B. Tailored Drug Delivery Platforms: Stimulus-Responsive Core–Shell Structured Nanocarriers. Adv. Healthc. Mater. 2024, 13, 2301726. [Google Scholar] [CrossRef] [PubMed]
- Okur, M.E.; Karantas, I.D.; Şenyiğit, Z.; Üstündağ Okur, N.; Siafaka, P.I. Recent Trends on Wound Management: New Therapeutic Choices Based on Polymeric Carriers. Asian J. Pharm. Sci. 2020, 15, 661–684. [Google Scholar] [CrossRef] [PubMed]
- Wu, Y.-K.; Cheng, N.-C.; Cheng, C.-M. Biofilms in Chronic Wounds: Pathogenesis and Diagnosis. Trends Biotechnol. 2019, 37, 505–517. [Google Scholar] [CrossRef] [PubMed]
- Fonder, M.A.; Lazarus, G.S.; Cowan, D.A.; Aronson-Cook, B.; Kohli, A.R.; Mamelak, A.J. Treating the Chronic Wound: A Practical Approach to the Care of Nonhealing Wounds and Wound Care Dressings. J. Am. Acad. Dermatol. 2008, 58, 185–206. [Google Scholar] [CrossRef]
- Zhao, R.; Liang, H.; Clarke, E.; Jackson, C.; Xue, M. Inflammation in Chronic Wounds. Int. J. Mol. Sci. 2016, 17, 2085. [Google Scholar] [CrossRef] [PubMed]
- Verbanic, S.; Shen, Y.; Lee, J.; Deacon, J.M.; Chen, I.A. Microbial Predictors of Healing and Short-Term Effect of Debridement on the Microbiome of Chronic Wounds. NPJ Biofilms Microbiomes 2020, 6, 21. [Google Scholar] [CrossRef]
- Huang, C.; Wang, M.; Yu, S.; Yu, D.-G.; Bligh, S.W.A. Electrospun Fenoprofen/Polycaprolactone @ Tranexamic Ac-id/Hydroxyapatite Nanofibers as Orthopedic Hemostasis Dressings. Nanomaterials 2024, 14, 646. [Google Scholar] [CrossRef]
- Zhu, Y.; Zhang, C.; Liang, Y.; Shi, J.; Yu, Q.; Liu, S.; Yu, D.G.; Liu, H. Advanced Postoperative Tissue Antiadhesive Membranes Enabled with Electrospun Nanofibers. Biomater. Sci. 2024, 17, 1643–1661. [Google Scholar] [CrossRef] [PubMed]
- Lv, Q.; Ma, X.; Zhang, C.; Han, J.; He, S.; Liu, K.; Jiang, S. Nanocellulose-Based Nanogenerators for Sensor Applications: A Review. Int. J. Biolog. Macromol. 2024, 259, 129268. [Google Scholar] [CrossRef]
- Zhang, Y.; Tang, Y.; Liao, Q.; Qian, Y.; Zhu, L.; Yu, D.G.; Xu, Y.; Lu, X.; Kim, I.; Song, W. Silver oxide decorated urchin-like microporous organic polymer composites as versatile antibacterial organic coating materials. J. Mater. Chem. B 2024, 12, 2054–2069. [Google Scholar] [CrossRef]
- Zhang, X.; Yu, N.; Ren, Q.; Niu, S.; Zhu, L.; Hong, L.; Cui, K.; Wang, X.; Jiang, W.; Wen, M.; et al. Janus Nanofiber Membranes with Photothermal-Enhanced Biofluid Drainage and Sterilization for Diabetic Wounds. Adv. Funct. Mater. 2024, 34, 2315020. [Google Scholar] [CrossRef]
- Dong, Y.; Zheng, Y.; Zhang, K.; Yao, Y.; Wang, L.; Li, X.; Yu, J.; Ding, B. Electrospun Nanofibrous Materials for Wound Healing. Adv. Fiber Mater. 2020, 2, 212–227. [Google Scholar] [CrossRef]
- Wu, H.; Yan, S.; Wang, Y.; Zhang, C. Preparation and Properties of Electrospun Chitosan/Polybutylenes Succinate Nanofiber Membrane for Wound Hemostatic Dressing. J. Ind. Text. 2022, 52, 152808372211130. [Google Scholar] [CrossRef]
- Unnithan, A.R.; Gnanasekaran, G.; Sathishkumar, Y.; Lee, Y.S.; Kim, C.S. Electrospun Antibacterial Polyurethane–Cellulose Acetate–Zein Composite Mats for Wound Dressing. Carbohydr. Polym. 2014, 102, 884–892. [Google Scholar] [CrossRef]
- Gao, C.; Zhang, L.; Wang, J.; Cheng, Y.; Chen, Z.; Yang, R.; Zhao, G. Coaxial Structured Drug Loaded Dressing Combined with Induced Stem Cell Differentiation for Enhanced Wound Healing. Biomater. Adv. 2022, 134, 112542. [Google Scholar] [CrossRef]
- Lv, H.; Liu, Y.; Zhou, J.; Bai, Y.; Shi, H.; Yue, B.; Shen, S.; Yu, D.G. Efficient Piezophotocatalysis of ZnO@PVDF Coaxial Nanofibers Modified with BiVO4 and Ag for the Simultaneous Generation of H2O2 and Removal of Pefloxacin and Cr(VI) in Water. Chem. Eng. J. 2024, 484, 149514. [Google Scholar] [CrossRef]
- Zhao, P.; Zhou, K.; Xia, Y.; Qian, C.; Yu, D.-G.; Xie, Y.; Liao, Y. Electrospun Trilayer Eccentric Janus Nanofibers for A Combined Treatment of Periodontitis. Adv. Fiber Mater. 2024, 5, 1–14. [Google Scholar] [CrossRef]
- Song, W.; Tang, Y.; Qian, C.; Kim, B.J.; Liao, Y.; Yu, D.-G. Electrospinning Spinneret: A Bridge between the Visible World and the Invisible Nanostructures. Innovation 2023, 4, 100381. [Google Scholar] [CrossRef] [PubMed]
- Yang, Y.; Zhang, R.; Liang, Z.; Guo, J.; Chen, B.; Zhou, S.; Yu, D. Application of Electrospun Drug-Loaded Nanofibers in Cancer Therapy. Polymers 2024, 16, 504. [Google Scholar] [CrossRef] [PubMed]
- Sun, L.; Zhou, J.; Chen, Y.; Yu, D.G.; Liu, P. A Combined Electrohydrodynamic Atomization Method for Preparing Nano-fiber/Microparticle Hybrid Medicines. Front. Bioeng. Biotechnol. 2023, 11, 1308004. [Google Scholar] [CrossRef] [PubMed]
- Duan, H.; Chen, H.; Qi, C.; Lv, F.; Wang, J.; Liu, Y.; Liu, Z.; Liu, Y. A Novel Electrospun Nanofiber System with PEGylated Paclitaxel Nanocrystals Enhancing the Transmucus Permeability and in situ Retention for an Efficient Cervicovaginal Cancer Therapy. Int. J. Pharm. 2024, 650, 123660. [Google Scholar] [CrossRef] [PubMed]
- Chen, X.; Liu, Y.; Liu, P. Electrospun Core–Sheath Nanofibers with a Cellulose Acetate Coating for the Synergistic Release of Zinc Ion and Drugs. Mol. Pharm. 2024, 21, 173–182. [Google Scholar] [CrossRef] [PubMed]
- Liu, Y.; Chen, X.; Lin, X.; Yan, J.; Yu, D.-G.; Liu, P.; Yang, H. Electrospun multi-chamber core–shell nanofibers and their controlled release behaviors: A review. WIREs Nanomed. Nanobiotechnol. 2024, 16, 1954. [Google Scholar] [CrossRef] [PubMed]
- Agrawal, G.; Agrawal, R. Janus Nanoparticles: Recent Advances in Their Interfacial and Biomedical Applications. ACS Appl. Nano Mater. 2019, 2, 1738–1757. [Google Scholar] [CrossRef]
- Lamberger, Z.; Zainuddin, S.; Scheibel, T.; Lang, G. Polymeric Janus Fibers. ChemPlusChem 2023, 88, e202200371. [Google Scholar] [CrossRef] [PubMed]
- Ndlovu, S.P.; Ngece, K.; Alven, S.; Aderibigbe, B.A. Gelatin-Based Hybrid Scaffolds: Promising Wound Dressings. Polymers 2021, 13, 2959. [Google Scholar] [CrossRef]
- Vatankhah, E.; Prabhakaran, M.P.; Jin, G.; Mobarakeh, L.G.; Ramakrishna, S. Development of Nanofibrous Cellulose Acetate/Gelatin Skin Substitutes for Variety Wound Treatment Applications. J. Biomater. Appl. 2014, 28, 909–921. [Google Scholar] [CrossRef]
- Khoshnevisan, K.; Maleki, H.; Samadian, H.; Shahsavari, S.; Sarrafzadeh, M.H.; Larijani, B.; Dorkoosh, F.A.; Haghpanah, V.; Khorramizadeh, M.R. Cellulose Acetate Electrospun Nanofibers for Drug Delivery Systems: Applications and Recent Advances. Carbohydr. Polym. 2018, 198, 131–141. [Google Scholar] [CrossRef] [PubMed]
- Baghersad, S.; Hivechi, A.; Bahrami, S.H.; Brouki Milan, P.; Siegel, R.A.; Amoupour, M. Optimal Aloe Vera Encapsulated PCL/Gel Nanofiber Design for Skin Substitute Application and the Evaluation of Its in Vivo Implantation. J. Drug Deliv. Sci. Technol. 2022, 74, 103536. [Google Scholar] [CrossRef]
- Hivechi, A.; Milan, P.B.; Modabberi, K.; Amoupour, M.; Ebrahimzadeh, K.; Gholipour, A.R.; Sedighi, F.; Amini, N.; Bahrami, S.H.; Rezapour, A.; et al. Synthesis and Characterization of Exopolysaccharide Encapsulated PCL/Gelatin Skin Substitute for Full-Thickness Wound Regeneration. Polymers 2021, 13, 854. [Google Scholar] [CrossRef] [PubMed]
- Espitia, P.J.P.; Soares, N.D.F.F.; Coimbra, J.S.D.R.; De Andrade, N.J.; Cruz, R.S.; Medeiros, E.A.A. Zinc Oxide Nanoparticles: Synthesis, Antimicrobial Activity and Food Packaging Applications. Food Bioprocess Technol. 2012, 5, 1447–1464. [Google Scholar] [CrossRef]
- Salehi, B.; Rodrigues, C.F.; Peron, G.; Dall’Acqua, S.; Sharifi-Rad, J.; Azmi, L.; Shukla, I.; Singh Baghel, U.; Prakash Mishra, A.; Elissawy, A.M.; et al. Curcumin Nanoformulations for Antimicrobial and Wound Healing Purposes. Phytother. Res. 2021, 35, 2487–2499. [Google Scholar] [CrossRef] [PubMed]
- Ki, C.S.; Baek, D.H.; Gang, K.D.; Lee, K.H.; Um, I.C.; Park, Y.H. Characterization of Gelatin Nanofiber Prepared from Gelatin–Formic Acid Solution. Polymer 2005, 46, 5094–5102. [Google Scholar] [CrossRef]
- Wang, H.; Hao, L.; Wang, P.; Chen, M.; Jiang, S.; Jiang, S. Release Kinetics and Antibacterial Activity of Curcumin Loaded Zein Fibers. Food Hydrocoll. 2017, 63, 437–446. [Google Scholar] [CrossRef]
- Shalumon, K.T.; Anulekha, K.H.; Nair, S.V.; Nair, S.V.; Chennazhi, K.P.; Jayakumar, R. Sodium Alginate/Poly(Vinyl Alcohol)/Nano ZnO Composite Nanofibers for Antibacterial Wound Dressings. Int. J. Biol. Macromol. 2011, 49, 247–254. [Google Scholar] [CrossRef]
- Ahmed, J.; Gultekinoglu, M.; Edirisinghe, M. Bacterial Cellulose Micro-Nano Fibres for Wound Healing Applications. Biotechnol. Adv. 2020, 41, 107549. [Google Scholar] [CrossRef]
- Lößlein, S.M.; Merz, R.; Müller, D.W.; Kopnarski, M.; Mücklich, F. An In-Depth Evaluation of Sample and Measurement Induced Influences on Static Contact Angle Measurements. Sci. Rep. 2022, 12, 19389. [Google Scholar] [CrossRef]
- Bettahar, F.; Bekkar, F.; Pérez-Álvarez, L.; Ferahi, M.I.; Meghabar, R.; Vilas-Vilela, J.L.; Ruiz-Rubio, L. Tough Hydrogels Based on Maleic Anhydride, Bulk Properties Study and Microfiber Formation by Electrospinning. Polymers 2021, 13, 972. [Google Scholar] [CrossRef] [PubMed]
- Tian, D.; He, C. From Inner Topological Structure to Functional Nanofibers: Theoretical Analysis and Experimental Verification. Membranes 2021, 11, 870. [Google Scholar] [CrossRef] [PubMed]
- Navarro Oliva, F.S.; Picart, L.; Leon-Valdivieso, C.Y.; Benalla, A.; Lenglet, L.; Ospina, A.; Jestin, J.; Bedoui, F. Coaxial Electrospinning Process toward Optimal Nanoparticle Dispersion in Polymeric Matrix. Polym. Compos. 2021, 42, 1565–1573. [Google Scholar] [CrossRef]
- Peng, W.; Wang, L.; Zhang, M.; Yu, D.G.; Li, X. Biodegradable Flexible Conductive Film Based on Sliver Nanowires and PLA Electrospun Fibers. J. Appl. Polym. Sci. 2024, e55433. [Google Scholar] [CrossRef]
- Qosim, N.; Majd, H.; Huo, S.; Edirisinghe, M.; Williams, G.R. Hydrophilic and Hydrophobic Drug Release from Core (Pol-yvinylpyrrolidone)-Sheath (Ethyl Cellulose) Pressure-Spun Fibers. Int. J. Pharm. 2024, 654, 123972. [Google Scholar] [CrossRef] [PubMed]
- Zhang, Y.; Lu, Y.; Li, Y.; Xu, Y.; Song, W. Poly(Glutamic Acid)-Engineered Nanoplatforms for Enhanced Cancer Photo-therapy. Curr. Drug Deliv. 2024, 21, 326–338. [Google Scholar] [CrossRef]
- Liao, Q.; Kim, E.J.; Tang, Y.; Xu, H.; Yu, D.G.; Song, W.; Kim, B.J. Rational Design of Hyper-Crosslinked Polymers for Bio-medical Applications. J. Polym. Sci. 2013, 8, 1459–1481. [Google Scholar] [CrossRef]
- Li, J.; Du, Q.; Wan, J.; Yu, D.G.; Tan, F.; Yang, X. Improved synergistic anticancer action of quercetin and tamoxifen citrate supported by an electrospun complex nanostructure. Mater. Des. 2024, 238, 112657. [Google Scholar] [CrossRef]
- Zhou, J.; Pan, H.; Gong, W.; Yu, D.G.; Sun, Y. Electrosprayed Eudragit RL100 nanoparticles with Janus polyvinylpyrrolidone patches for multiphase release of paracetamol. Nanoscale 2024, 17. [Google Scholar] [CrossRef]
- Chen, S.; Zhou, J.; Fang, B.; Ying, Y.; Yu, D.G.; He, H. Three EHDA Processes from A Detachable Spinneret for Fabricating Drug Fast Dissolution Composites. Macromol. Mater. Eng. 2023, 309, 2300361. [Google Scholar] [CrossRef]
- Kwiatkowska, A.; Drabik, M.; Lipko, A.; Grzeczkowicz, A.; Stachowiak, R.; Marszalik, A.; Granicka, L.H. Composite Mem-brane Dressings System with Metallic Nanoparticles as an Antibacterial Factor in Wound Healing. Membranes 2022, 12, 215. [Google Scholar] [CrossRef] [PubMed]

| Group | Crescent Side (w/v) | Circular Side (w/v) | Flow Rate (mL/h) | Voltage (kV) |
|---|---|---|---|---|
| CA | / | 12% CA | 1.5 | 9.0 |
| Gel | / | 14% Gel | 1.5 | 8.5 |
| F0 | 12% CA | 14% Gel | 1.5:1.5 | 9.5 |
| F1 | 12% CA + 2% CUR | 14% Gel | 1.5:1.5 | 9.5 |
| F2 | 12% CA + 2% ZnO | 14% Gel | 1.5:1.5 | 9.5 |
Disclaimer/Publisher’s Note: The statements, opinions and data contained in all publications are solely those of the individual author(s) and contributor(s) and not of MDPI and/or the editor(s). MDPI and/or the editor(s) disclaim responsibility for any injury to people or property resulting from any ideas, methods, instructions or products referred to in the content. |
© 2024 by the authors. Licensee MDPI, Basel, Switzerland. This article is an open access article distributed under the terms and conditions of the Creative Commons Attribution (CC BY) license (https://creativecommons.org/licenses/by/4.0/).
Share and Cite
Huang, T.; Zeng, Y.; Li, C.; Zhou, Z.; Liu, Y.; Xu, J.; Wang, L.; Yu, D.-G.; Wang, K. Preparation and Investigation of Cellulose Acetate/Gelatin Janus Nanofiber Wound Dressings Loaded with Zinc Oxide or Curcumin for Enhanced Antimicrobial Activity. Membranes 2024, 14, 95. https://doi.org/10.3390/membranes14050095
Huang T, Zeng Y, Li C, Zhou Z, Liu Y, Xu J, Wang L, Yu D-G, Wang K. Preparation and Investigation of Cellulose Acetate/Gelatin Janus Nanofiber Wound Dressings Loaded with Zinc Oxide or Curcumin for Enhanced Antimicrobial Activity. Membranes. 2024; 14(5):95. https://doi.org/10.3390/membranes14050095
Chicago/Turabian StyleHuang, Tianyue, YuE Zeng, Chaofei Li, Zhengqing Zhou, Yukang Liu, Jie Xu, Lean Wang, Deng-Guang Yu, and Ke Wang. 2024. "Preparation and Investigation of Cellulose Acetate/Gelatin Janus Nanofiber Wound Dressings Loaded with Zinc Oxide or Curcumin for Enhanced Antimicrobial Activity" Membranes 14, no. 5: 95. https://doi.org/10.3390/membranes14050095
APA StyleHuang, T., Zeng, Y., Li, C., Zhou, Z., Liu, Y., Xu, J., Wang, L., Yu, D.-G., & Wang, K. (2024). Preparation and Investigation of Cellulose Acetate/Gelatin Janus Nanofiber Wound Dressings Loaded with Zinc Oxide or Curcumin for Enhanced Antimicrobial Activity. Membranes, 14(5), 95. https://doi.org/10.3390/membranes14050095






